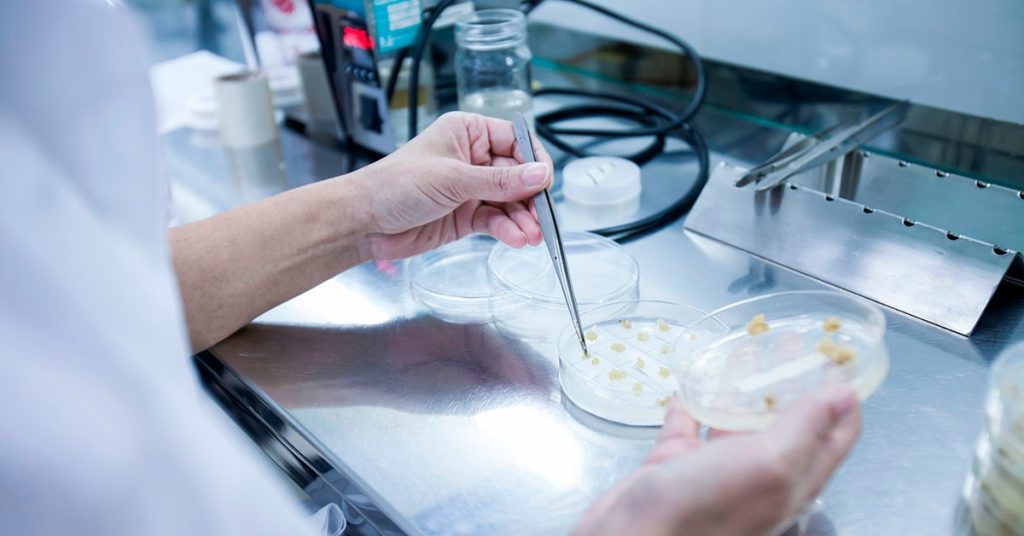

Redução de benefícios tributários federais impacta setor produtivo em Minas Gerais
A redução linear de incentivos e benefícios fiscais concedidos pela União, que entrou em vigor em 1º de janeiro, deve impactar negativamente setores produtivos em Minas Gerais, em especial, aqueles dependentes da importação de maquinários e os que possuem regime fiscal próprio, como é o caso da indústria química.
As mudanças foram regulamentadas pela Instrução Normativa RFB nº 2.305, publicada pela Receita Federal em 31 de dezembro de 2025. Ao reduzir incentivos fiscais, a medida acaba elevando os custos de produção, o que exige das empresas a adoção de ajustes para minimizar os efeitos sobre a operação.
Leia também: Decreto regulamenta redução de incentivos tributários federais
A analista tributária sênior da Gerência Tributária da Federação das Indústrias do Estado de Minas Gerais (Fiemg), Gabriela Cristina Figueredo, alerta que o encarecimento de insumos e equipamentos deve afetar os investimentos e a capacidade de expansão da indústria.
“A redução prevista na nova legislação atinge diretamente benefícios sobre importação (PIS/Cofins-Importação, Imposto de Importação e IPI), diminuindo as condições mais favoráveis ao investimento”, explica.
O resultado, segundo a especialista, é o aumento nos custos de aquisição de maquinário, equipamentos e tecnologia importados. Esse avanço poderá retardar, encarecer ou inviabilizar projetos de expansão e modernização da indústria.
Veja quais tributos serão impactados:
- Programa de Integração Social (PIS);
- Programa de Formação do Patrimônio do Servidor Público (Pasep);
- Contribuição para o Financiamento da Seguridade Social (Cofins);
- Imposto de Renda da Pessoa Jurídica (IRPJ);
- Contribuição Social sobre o Lucro Líquido (CSLL);
- Imposto de Importação (II);
- Imposto sobre Produtos Industrializados (IPI).
A nova norma já está em vigor para o IRPJ e para o imposto de importação. Para os demais tributos, começa a valer a partir de 1º de abril. A normativa ainda determina como deverá ser realizada a aplicação da redução para empresas tributadas pelo lucro presumido cuja receita bruta seja superior a R$ 5 milhões no respectivo ano-calendário. O principal objetivo da alteração é proporcionar maior responsabilidade fiscal ao governo federal.
O professor de Direito Tributário da Universidade Federal de Minas Gerais (UFMG) Valter Lobato destaca a nova norma atingirá, praticamente, todos os setores da economia brasileira. As exceções serão a cesta básica, a Zona Franca de Manaus (AM) e demais imunidades constitucionais. “Todo o resto que possui algum tipo de incentivo federal terá uma redução de 10%. Isso atingirá até o grupo do lucro presumido”, completa.
Para Lobato, essa alteração chega em um momento em que o empresariado já enfrenta um avanço expressivo da carga tributária.
Já o advogado tributarista e professor de direito tributário na PUC Minas Antônio Carlos Castro recomenda que as empresas optantes pelo regime de apuração tributária do lucro presumido sejam ainda mais cuidadosas, principalmente, na análise sobre permanência ou mudança para o regime de lucro real. “Com o aumento das despesas, a necessidade da realização de um planejamento tributário também se faz importante”, diz.
O que as empresas podem fazer para mitigar efeitos

Apesar do cenário desafiador, existem algumas estratégias que podem ajudar a mitigar os efeitos desse aumento da carga tributária. Entre as alternativas, Gabriela Figueredo menciona a revisão tributária acompanhada de um planejamento fiscal eficiente, identificando oportunidades de otimização.
Na visão da analista tributária da Fiemg, a revisão de contratos com fornecedores, processos produtivos e estratégias comerciais pode contribuir para aumentar a eficiência e manter a competitividade neste cenário desafiador.
Ouça a rádio de Minas